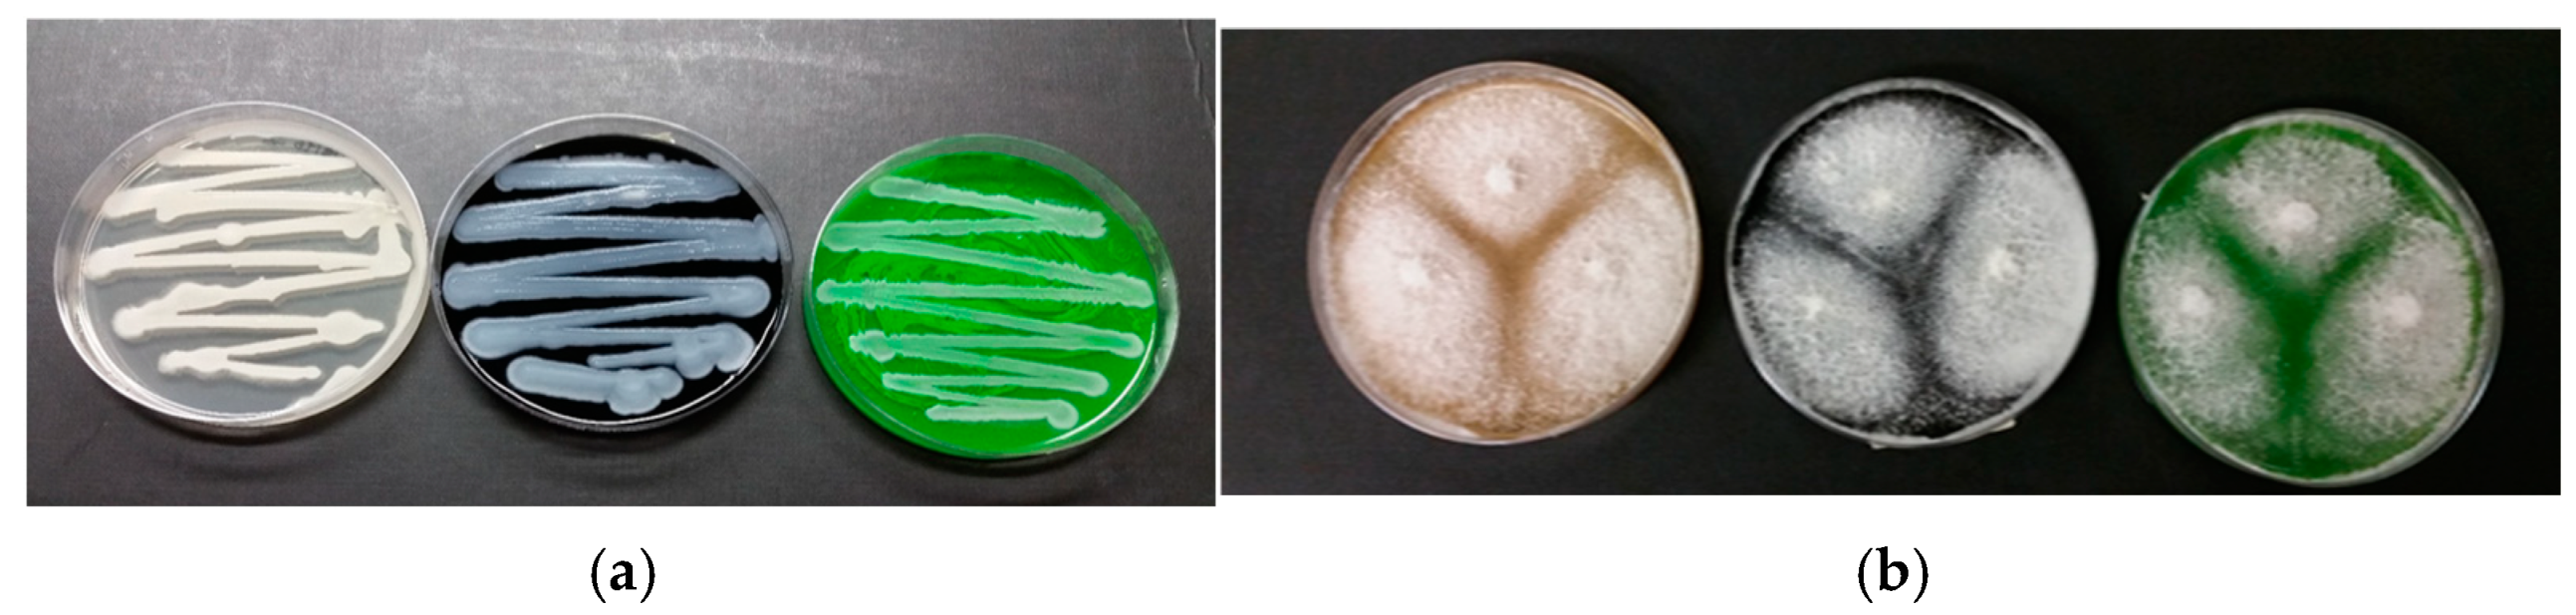
Molecules 29 05543 g009

Investigation on Tattoo Ink (Hexadecachlorinate Copper Phthalocyanine) Removal: Novel Chemical and Biological Approach
Abstract
1. Introduction
| When | Where (Country) | Who | Why (Significance) | Refs |
|---|---|---|---|---|
| Ancient and traditional use | Greece, Rome, Italy, and Austria (Alps) | Otzi | Mummified human | [10] |
| North America | Indigenous People | Skin modifications | [11] | |
| Inuit | Symbolize a girl transitioning into a woman | [12,13] | ||
| Osage People | Man, as smaller cycle of life | [14] | ||
| Iroquois People | Cultural significance of the Manitou—Warfare | [15] | ||
| Central America | ||||
| Taiwan | ||||
| Philippines | Head hunting | [16,17] | ||
| Solomon Islands | Historical events | [17] | ||
| Japan | Samurai, Criminals | Samurai’s bravery and loyalty; offenses of the underworld | [18] | |
| China | Various aspects of social life | [19] | ||
| Egypt Nubia, Copts | Religion aspects | [20] | ||
| Modern tattooing | Reintroduction to the Western world pre-1860s | British Court British Sailors | [21] | |
| Early United States | The Tattoo Renaissance | [22] | ||
| Indigenous Boarding School Tattooing Practices | [23] | |||
| Military sectors | United States | Luck, protection, wartime experience, or enhance their combat abilities | [24,25] |
2. Results and Discussion
2.1. FTIR-ATR Analysis of Inks
2.2. Microorganisms and Enrichment Culture Technique
2.2.1. Enrichment Test Culture
2.2.2. Microbial Community Analysis
2.2.3. Py-GC/MS Analysis on “Azayaka True Green Dispersion”
2.2.4. NMR Analysis
2.2.5. FTIR-ATR Analysis on “Azayaka True Green Dispersion”
2.3. Biological Removal of Inks
2.4. Pool Enzymatic Profile on Activated Biogel
2.5. Green Ink Removal on Pork Rind by Pure Microbial Cultures
2.6. Electrochemical Removal of Green Ink from Wastewater
2.7. Environmental Impact, CO2 Equivalent Emissions, and Mitigation Actions
3. Materials and Methods
3.1. Experimental Design
3.2. Tattoo Inks
3.3. Chemical and Physical Parameters
3.4. Chemical Analyses Using Infrared Spectroscopy
3.5. Chemical Characterization by Py-GC/MS
3.6. Sample Preparation and NMR Experiments
3.7. Tattoo Device
3.8. In Vitro Tattoos on Pork Rind, at Lab Scale
3.9. Microorganisms, Cultural Media, and Environmental Inocula
3.10. Extraction of Genomic DNA from Inocula Samples
3.11. Optical Microscope Observation
3.12. Color Measurements
3.13. Electrolytic Equipment Adopted for Green Ink in Water Solution
3.14. Environmental Impact
4. Conclusions
Supplementary Materials
Author Contributions
Funding
Institutional Review Board Statement
Informed Consent Statement
Data Availability Statement
Acknowledgments
Conflicts of Interest
References
- Poon, K.W.C.; Dadour, I.R.; McKinley, A.J. In situ chemical analysis of modern organic tattooing inks and pigments by micro-Raman spectroscopy. J. Raman Spectrosc. 2008, 39, 1227–1237. [Google Scholar] [CrossRef]
- Miranda, M.D. Tattoos and tattoo inks: Forensic considerations. WIREs Forensic Sci. 2020, 2, e1360. [Google Scholar] [CrossRef]
- Moehrle, M.; Blaheta, H.J.; Ruck, P. Tattoo Pigment Mimics Positive Sentinel Lymph Node in Melanoma. Dermatology 2001, 203, 342–344. [Google Scholar] [CrossRef]
- Friedman, T.; Westreich, M.; Mozes, S.N.; Dorenbaum, A.; Herman, O. Tattoo Pigment in Lymph Nodes Mimicking Metastatic Malignant Melanoma. Plast. Reconstr. Surg. 2003, 111, 2120–2122. [Google Scholar] [CrossRef]
- Vasold, R.; Engel, E.; König, B.; Landthaler, M.; Bäumler, W. Health risks of tattoo colors. Anal. Bioanal. Chem. 2008, 391, 9–13. [Google Scholar] [CrossRef]
- Nielsen, C.; Jerkeman, M.; Jöud, A.S. Tattoos as a risk factor for malignant lymphoma: A population-based case–control study. eClinicalMedicine 2024, 72, 102649. [Google Scholar] [CrossRef]
- Cui, Y.; Spann, A.P.; Couch, L.H.; Gopee, N.V.; Evans, F.E.; Churchwell, M.I.; Williams, L.D.; Doerge, D.R.; Howard, P.C. Photodecomposition of Pigment Yellow 74, a Pigment Used in Tattoo Inks¶. Photochem. Photobiol. 2004, 80, 175. [Google Scholar] [CrossRef]
- Vasold, R.; Naarmann, N.; Ulrich, H.; Fischer, D.; König, B.; Landthaler, M.; Bäumler, W. Tattoo pigments are cleaved by laser light—The chemical analysis in vitro provide evidence for hazardous compounds. Photochem. Photobiol. 2004, 80, 185–190. [Google Scholar] [CrossRef]
- Renzoni, A.; Pirrera, A.; Novello, F.; Lepri, A.; Cammarata, P.; Tarantino, C.; D’Ancona, F.; Perra, A. The tattooed population in Italy: A national survey on demography, characteristics and perception of health risks. Ann. Ist. Super. Sanita 2018, 54, 126–136. [Google Scholar] [CrossRef]
- Deter-Wolf, A.; Robitaille, B.; Krutak, L.; Galliot, S. The world’s oldest tattoos. J. Archaeol. Sci. Reports 2016, 5, 19–24. [Google Scholar] [CrossRef]
- Diaz-Granados, C.; Deter-Wolf, A. Introduction. In Drawing with Great Needles; Deter-Wolf, A., Diaz-Granados, C., Eds.; University of Texas Press: Austin, TX, USA, 2013; pp. xi–xv. [Google Scholar]
- Oosten, J.; Laugrand, F. The bringer of light: The raven in Inuit tradition. Polar Rec. 2006, 42, 187–204. [Google Scholar] [CrossRef]
- Arnaquq-Baril, A. Tunniit: Retracing the Lines of Inuit Tattoos; Unikkaat Studios Inc.: Iqaluit, NU, Canada, 2010. [Google Scholar]
- Dye, D.H. Snaring Life from the Star and the Sun. In Drawing with Great Needles: Ancient Tattoo Traditions of North America.; Deter-Wolf, A., Diaz-Granados, C., Eds.; University of Texas Press: Austin, TX, USA, 2013; pp. 215–251. [Google Scholar]
- Krutak, L. Tattoos, Totem Marks, and War Clubs. In Drawing with Great Needles: Ancient Tattoo Traditions of North America.; Deter-Wolf, A., Diaz-Granados, C., Eds.; University of Texas Press: Austin, TX, USA, 2013; pp. 95–130. [Google Scholar]
- Soukup, M.; Lužný, D.; Bláha, J.D.; Skupnik, J. The aura of tattoos: The commodification of tradition in Buscalan village, the Philippines. Asian J. Soc. Sci. 2021, 49, 153–160. [Google Scholar] [CrossRef]
- Baldick, J. Ancient Religions of the Austronesian World: From Australasia to Taiwan; I.B. Tauri.; Bloomsbury Publishing: London, UK, 2013; ISBN 9781780763668. [Google Scholar]
- Skutlin, J. Fashioning Tattooed Bodies: An Exploration of Japan’s Tattoo Stigma. Asia Pacific Perspect. 2019, 16, 4–33. [Google Scholar]
- Reed, C.E. Tattoo in Early China. J. Am. Orient. Soc. 2000, 120, 360. [Google Scholar] [CrossRef]
- Tadros, M. Heritage practices as development’s blind spot: A case study of Coptic tattooing in Libya and Egypt. Dev. Policy Rev. 2022, 40, e12598. [Google Scholar] [CrossRef]
- Jablonski, N.G. Skin: A Natural History; Illustrate; University of California Press: Oakland, CA, USA, 2006. [Google Scholar]
- Velliquette, A.M.; Murray, J.B.; Creyer, E.H. The Tattoo Renaissance: An Ethnographic Account of Symbolic Consumer Behavior. Adv. Consum. Res. 1998, 25, 451–467. [Google Scholar]
- Dawley, M.M. Indian Boarding School Tattooing Experiences: Resistance, Power, and Control through Personal Narratives. Am. Indian Q. 2020, 44, 279. [Google Scholar] [CrossRef]
- Dyvik, S.L.; Welland, J. War Ink: Sense-Making and Curating War through Military Tattoos. Int. Polit. Sociol. 2018, 12, 346–361. [Google Scholar] [CrossRef]
- Lande, R.G.; Bahroo, B.A.; Soumoff, A. United States Military Service Members and Their Tattoos: A Descriptive Study. Mil. Med. 2013, 178, 921–925. [Google Scholar] [CrossRef]
- Karadagli, S.S.; Cansever, I.; Armagan, G.; Sogut, O. Are Some Metals in Tattoo Inks Harmful to Health? An Analytical Approach. Chem. Res. Toxicol. 2023, 36, 104–111. [Google Scholar] [CrossRef]
- Engel, E.; Santarelli, F.; Vasold, R.; Ulrich, H.; Maisch, T.; König, B.; Landthaler, M.; Gopee, N.V.; Howard, P.C.; Bäumler, W. Establishment of an Extraction Method for the Recovery of Tattoo Pigments from Human Skin Using HPLC Diode Array Detector Technology. Anal. Chem. 2006, 78, 6440–6447. [Google Scholar] [CrossRef] [PubMed]
- Gopee, N.V.; Cui, Y.; Olson, G.; Warbritton, A.R.; Miller, B.J.; Couch, L.H.; Wamer, W.G.; Howard, P.C. Response of mouse skin to tattooing: Use of SKH-1 mice as a surrogate model for human tattooing. Toxicol. Appl. Pharmacol. 2005, 209, 145–158. [Google Scholar] [CrossRef]
- Bäumler, W. Absorption, Distribution, Metabolism and Excretion of Tattoo Colorants and Ingredients in Mouse and Man: The Known and the Unknown. In Tattooed Skin and Health; Serup, J., Kluger, N., Bäumler, W., Eds.; S.Karger AG: Basel, Switzerland, 2015; pp. 176–184. ISBN 978-3-318-02776-1. [Google Scholar]
- Foerster, M.; Dufour, L.; Bäumler, W.; Schreiver, I.; Goldberg, M.; Zins, M.; Ezzedine, K.; Schüz, J. Development and Validation of the Epidemiological Tattoo Assessment Tool to Assess Ink Exposure and Related Factors in Tattooed Populations for Medical Research: Cross-sectional Validation Study. JMIR Form. Res. 2023, 7, e42158. [Google Scholar] [CrossRef]
- OʼDonnell, M.B.P.; Mulvaney, M.J.; James, C.W.D.; McMarlin, C.S.L. Thin Tangential Excision of Tattoos. Dermatol. Surg. 1995, 21, 601–604. [Google Scholar] [CrossRef]
- Zelickson, B.D.; Mehregan, D.A.; Zarrin, A.A.; Coles, C.; Hartwig, P.; Olson, S.; Leaf-Davis, J. Clinical, histologic, and ultrastructural evaluation of tattoos treated with three laser systems. Lasers Surg. Med. 1994, 15, 364–372. [Google Scholar] [CrossRef]
- Chen, S.-C. Assessment of Genotoxicity of Benzidine and Its Structural Analogues to Human Lymphocytes Using Comet Assay. Toxicol. Sci. 2003, 72, 283–288. [Google Scholar] [CrossRef][Green Version]
- Huang, Q.-G.; Kong, L.-R.; Liu, Y.-B.; Wang, L.-S. Relationships Between Molecular Structure and Chromosomal Aberrations in In Vitro Human Lymphocytes Induced by Substituted Nitrobenzenes. Bull. Environ. Contam. Toxicol. 1996, 57, 349–353. [Google Scholar] [CrossRef]
- Shimizu, H. Liver dysfunction among workers handling 5-nitro-o-toluidine. Gut 2002, 50, 266–270. [Google Scholar] [CrossRef] [PubMed][Green Version]
- Bourgeois, P.; Roman, M.M.; Schweicher, J.; Lavoisier, P.; Maquet, P.; Karler, C.; Lizewski, M.; Fouarge, A.; Cuylits, N.; del Marmol, V.; et al. Lymphatic Alterations Under Tattoos: Preliminary Reports of One Observational Study. Clin. Cosmet. Investig. Dermatol. 2023, 16, 257–265. [Google Scholar] [CrossRef]
- Serup, J.; Carlsen, K.H.; Sepehri, M. Tattoo complaints and complications: Diagnosis and clinical spectrum. Curr. Probl. Dermatol. 2015, 48, 48–60. [Google Scholar] [CrossRef]
- Giulbudagian, M.; Schreiver, I.; Singh, A.V.; Laux, P.; Luch, A. Safety of tattoos and permanent make-up: A regulatory view. Arch. Toxicol. 2020, 94, 357–369. [Google Scholar] [CrossRef]
- Sayama, M.; Mori, M.; Shoji, M.; Uda, S.; Kakikawa, M.; Kondo, T.; Kodaira, K.-I. Mutagenicities of 2,4- and 2,6-dinitrotoluenes and their reduced products in Salmonella typhimurium nitroreductase- and O-acetyltransferase-overproducing Ames test strains. Mutat. Res. Toxicol. Environ. Mutagen. 1998, 420, 27–32. [Google Scholar] [CrossRef] [PubMed]
- Polefka, T.G.; Meyer, T.A.; Agin, P.P.; Bianchini, R.J. Effects of Solar Radiation on the Skin. J. Cosmet. Dermatol. 2012, 11, 134–143. [Google Scholar] [CrossRef] [PubMed]
- Bauer, E.M.; Scibetta, E.V.; Cecchetti, D.; Piccirillo, S.; Antonaroli, S.; Sennato, S.; Cerasa, M.; Tagliatesta, P.; Carbone, M. Treatments of a phthalocyanine-based green ink for tattoo removal purposes: Generation of toxic fragments and potentially harmful morphologies. Arch. Toxicol. 2020, 94, 2359–2375. [Google Scholar] [CrossRef] [PubMed]
- Ho, S.; Goh, C. Laser tattoo removal: A clinical update. J. Cutan. Aesthet. Surg. 2015, 8, 9. [Google Scholar] [CrossRef]
- Bauer, E.M.; Cecchetti, D.; Guerriero, E.; Quaranta, S.; Ripanti, F.; Postorino, P.; Tagliatesta, P.; Carbone, M. “For Asia Market Only”: A Green Tattoo Ink between Safety and Regulations. Molecules 2022, 27, 3491. [Google Scholar] [CrossRef]
- Lee, S.U.; Kim, J.C.; Mizuseki, H.; Kawazoe, Y. The Origin of the Halogen Effect on the Phthalocyanine Green Pigments. Chem.–An Asian J. 2010, 5, 1341–1346. [Google Scholar] [CrossRef] [PubMed]
- Lomax, S.Q. Phthalocyanine and quinacridone pigments: Their history, properties and use. Stud. Conserv. 2005, 50, 19–29. [Google Scholar] [CrossRef]
- Squires, A.D.; Lewis, R.A. Terahertz Analysis of Phthalocyanine Pigments. J. Infrared Millim. Terahertz Waves 2019, 40, 738–751. [Google Scholar] [CrossRef]
- Bauer, E.M.; De Caro, T.; Tagliatesta, P.; Carbone, M. Unraveling the real pigment composition of tattoo inks: The case of bi-components phthalocyanine based greens. Dye. Pigment. 2019, 167, 225–235. [Google Scholar] [CrossRef]
- Ortiz-Herrero, L.; Cardaba, I.; Setien, S.; Bartolomé, L.; Alonso, M.L.; Maguregui, M.I. OPLS multivariate regression of FTIR-ATR spectra of acrylic paints for age estimation in contemporary artworks. Talanta 2019, 205, 120114. [Google Scholar] [CrossRef]
- Ortiz-Herrero, L.; Cardaba, I.; Bartolomé, L.; Alonso, M.L.; Maguregui, M.I. Extension study of a statistical age prediction model for acrylic paints. Polym. Degrad. Stab. 2020, 179, 109263. [Google Scholar] [CrossRef]
- Bugini, R.; Corti, C.; Folli, L.; Rampazzi, L. Roman Wall Paintings: Characterisation of Plaster Coats Made of Clay Mud. Heritage 2021, 4, 889–905. [Google Scholar] [CrossRef]
- Brunello, V.; Corti, C.; Sansonetti, A.; Tedeschi, C.; Rampazzi, L. Non-invasive FTIR study of mortar model samples: Comparison among innovative and traditional techniques. Eur. Phys. J. Plus 2019, 134, 270. [Google Scholar] [CrossRef]
- Learner, T.J.S. Analysis of Modern Paints; Research i; Getty Conservation Institute: Los Angeles, CA, USA, 2005; ISBN 978-0-89236-779-5. [Google Scholar]
- Lomax, S.Q.; Schilling, M.R.; Learner, T.J.S. The Identification of Synthetic Organic Pigments by FTIR and DTMS. In Modern Paints Uncovered; Learner, T.J.S., Smithen, P., Krueger, W.J., Schilling, M.R., Eds.; Getty Conservation Institute: Los Angeles, CA, USA, 2007; pp. 105–117. ISBN 978-0-89236-906-5. [Google Scholar]
- Lake, S.; Lomax, S.Q. Arylide (Hansa) Yellow Pigments. In Artists’ Pigments: A Handbook of their History and Characteristics; Berrie, B.H., Ed.; National Gallery of Art in association—Archetype Publications Ltd.: London, UK, 2007; p. 252. ISBN 9781904982234. [Google Scholar]
- Pöllnitz, G.; Schreiner, M.; Vetter, W.; Pichler, B.; Jastrzębiowski, A. Uncovering the illegible: Multi-analytical approach to reveal paint stratigraphy of corroded signposts from the Auschwitz-Birkenau State Museum. Herit. Sci. 2019, 7, 98. [Google Scholar] [CrossRef]
- Steger, S.; Stege, H.; Bretz, S.; Hahn, O. Capabilities and limitations of handheld Diffuse Reflectance Infrared Fourier Transform Spectroscopy (DRIFTS) for the analysis of colourants and binders in 20th-century reverse paintings on glass. Spectrochim. Acta Part A Mol. Biomol. Spectrosc. 2018, 195, 103–112. [Google Scholar] [CrossRef]
- Madhuri, R.J.; Saraswathi, M.; Gowthami, K.; Bhargavi, M.; Divya, Y.; Deepika, V. Recent Approaches in the Production of Novel Enzymes from Environmental Samples by Enrichment Culture and Metagenomic Approach. In Recent Developments in Applied Microbiology and Biochemistry; Elsevier: Amsterdam, The Netherlands, 2019; pp. 251–262. [Google Scholar]
- Bosch-Roig, P.; Decorosi, F.; Giovannetti, L.; Ranalli, G.; Viti, C. Connecting phenome to genome in Pseudomonas stutzeri 5190: An artwork biocleaning bacterium. Res. Microbiol. 2016, 167, 757–765. [Google Scholar] [CrossRef]
- Bosch-Roig, P.; Allegue, H.; Bosch, I. Granite pavement nitrate desalination: Traditional methods vs. biocleaning methods. Sustainability 2019, 11, 4227. [Google Scholar] [CrossRef]
- Ranalli, G.; Andreotti, A.; Colombini, M.P.; Corti, C.; Lima, G.; Rampazzi, L.; Saviano, G.; Vitullo, D.; Palmieri, D.; Zanardini, E. Biodeterioration of carbographic ribbon: Isolation, identification of causal agents and forensic implications. J. Appl. Microbiol. 2022, 133, 1843–1856. [Google Scholar] [CrossRef] [PubMed]
- Ghelardi, E.; Degano, I.; Colombini, M.P.; Mazurek, J.; Schilling, M.; Learner, T. Py-GC/MS Applied to the Analysis of Synthetic Organic Pigments: Characterization and Identification in Paint Samples. Anal. Bioanal. Chem. 2015, 407, 1415–1431. [Google Scholar] [CrossRef] [PubMed]
- Timko, A.L.; Miller, C.H.; Johnson, F.B.; Ross, E. In vitro quantitative chemical analysis of tattoo pigments. Arch. Dermatol. 2001, 137, 143–147. [Google Scholar]
- Colboc, H.; Bazin, D.; Reguer, S.; Lucas, I.T.; Moguelet, P.; Amode, R.; Jouanneau, C.; Soria, A.; Chasset, F.; Amsler, E.; et al. Chemical characterization of inks in skin reactions to tattoo. J. Synchrotron Radiat. 2022, 29, 1436–1445. [Google Scholar] [CrossRef]
- Gu, J.-D. On Enrichment Culturing and Transferring Technique. Appl. Environ. Biotechnol. 2021, 6, 1–5. [Google Scholar] [CrossRef]
- Alfano, G.; Lustrato, G.; Belli, C.; Zanardini, E.; Cappitelli, F.; Mello, E.; Sorlini, C.; Ranalli, G. The bioremoval of nitrate and sulfate alterations on artistic stonework: The case-study of Matera Cathedral after six years from the treatment. Int. Biodeterior. Biodegrad. 2011, 65, 1004–1011. [Google Scholar] [CrossRef]
- Cappitelli, F.; Toniolo, L.; Sansonetti, A.; Gulotta, D.; Ranalli, G.; Zanardini, E.; Sorlini, C. Advantages of Using Microbial Technology over Traditional Chemical Technology in Removal of Black Crusts from Stone Surfaces of Historical Monuments. Appl. Environ. Microbiol. 2007, 73, 5671–5675. [Google Scholar] [CrossRef]
- Cappitelli, F.; Zanardini, E.; Ranalli, G.; Mello, E.; Daffonchio, D.; Sorlini, C. Improved Methodology for Bioremoval of Black Crusts on Historical Stone Artworks by Use of Sulfate-Reducing Bacteria. Appl. Environ. Microbiol. 2006, 72, 3733–3737. [Google Scholar] [CrossRef]
- Palmieri, M.; Lasserre, B.; Marino, D.; Quaranta, L.; Raffi, M.; Ranalli, G. The Environmental Footprint of Scientific Research: Proposals and Actions to Increase Sustainability and Traceability. Sustainability 2023, 15, 5616. [Google Scholar] [CrossRef]
- Liberatore, L.; Bressan, M.; Belli, C.; Lustrato, G.; Ranalli, G. Chemical and Biological Combined Treatments for the Removal of Pesticides from Wastewaters. Water Air Soil Pollut. 2012, 223, 4751–4759. [Google Scholar] [CrossRef]
- Ranalli, G.; Belli, C.; Lustrato, G.; Pizzella, L.; Liberatore, L.; Bressan, M. Effects of Combined Chemical and Biological Treatments on the Degradability of Vulcanization Accelerators. Water. Air. Soil Pollut. 2008, 192, 199–209. [Google Scholar] [CrossRef]
- Andreotti, A.; Bonaduce, I.; Colombini, M.P.; Modugno, F.; Ribechini, E. A diagnosis of the yellowing of the marble high reliefs and the black decorations in the chapel of the tomb of Saint Anthony (Padua, Italy). Int. J. Mass Spectrom. 2009, 284, 123–130. [Google Scholar] [CrossRef]
- Saviano, G.; Paris, D.; Melck, D.; Falasca, A.; Trupiano, D.; Iorizzi, M.; Scippa, G.S.; Motta, A. Monitoring spatial and temporal metabolic dynamics of woody poplar root under mechanical stress conditions by NMR-based metabolomics. Metabolomics 2016, 12, 65. [Google Scholar] [CrossRef]
- Caprari, C.; Bucci, A.; Ciotola, A.C.; Del Grosso, C.; Dell’Edera, I.; Di Bartolomeo, S.; Di Pilla, D.; Divino, F.; Fortini, P.; Monaco, P.; et al. Microbial Biocontrol Agents and Natural Products Act as Salt Stress Mitigators in Lactuca sativa L. Plants 2024, 13, 2505. [Google Scholar] [CrossRef]
- Bergey, D.H.; Holt, J.G. Bergey’s Manual of Determinative Bacteriology; Lippincott Williams & Wilkins: Philadelphia, PA, USA, 2000; ISBN 9780683006032. [Google Scholar]
- Viti, C.; Mini, A.; Ranalli, G.; Lustrato, G.; Giovannetti, L. Response of microbial communities to different doses of chromate in soil microcosms. Appl. Soil Ecol. 2006, 34, 125–139. [Google Scholar] [CrossRef]
- Marasco, R.; Michoud, G.; Seferji, K.A.; Gonella, E.; Garuglieri, E.; Rolli, E.; Alma, A.; Mapelli, F.; Borin, S.; Daffonchio, D.; et al. Sorlinia euscelidii gen. nov., sp. nov., a Novel Acetic Acid Bacterium Isolated From the Leafhopper Euscelidius variegatus (Hemiptera: Cicadellidae). Int. J. Syst. Evol. Microbiol. 2024, 74, 006544. [Google Scholar] [CrossRef]
- Ranalli, G.; Bosch-Roig, P.; Crudele, S.; Rampazzi, L.; Corti, C.; Zanardini, E. Dry biocleaning of artwork: An innovative methodology for Cultural Heritage recovery? Microb. Cell 2021, 8, 91–105. [Google Scholar] [CrossRef]
- Sanmartín, P.; Villa, F.; Silva, B.; Cappitelli, F.; Prieto, B. Color Measurements as a Reliable Method for Estimating Chlorophyll Degradation to Phaeopigments. Biodegradation. 2011, 22, 763–771. [Google Scholar] [CrossRef]

| P. stutzeri 5190DSMZ | A. infectoria NIS4 | Soil, Compost Inocula | Ink Tattoo | |||
|---|---|---|---|---|---|---|
| Added Ink | Yes | No | Yes | No | Yes | Green |
| M9 | + | − | + | − | +/− | |
| PCA | + | ++ | nd | nd | − | |
| PDA | nd | nd | ++ | ++ | − | |
| M9 | + | - | + | - | +/− | Carbon black |
| PCA | + | ++ | nd | nd | − | |
| PDA | nd | nd | ++ | ++ | − | |
| Ink | Color Change | BTA vs. BTB | p | AC vs. BC | p |
|---|---|---|---|---|---|
| Green | ΔL* | 26.40 | 0.032 | −1.13 | 0.045 |
| Δa* | 8.90 | 0.040 | 0.32 | 0.038 | |
| Δb* | 5.40 | 0.048 | 0.90 | 0.032 | |
| ∆E*ab | 28.80 | 0.026 | 1.47 | 0.028 | |
| Carbon black | ΔL* | −0.45 | 0.078 | −0.75 | 0.065 |
| Δa* | −1.93 | 0.082 | −0.36 | 0.077 | |
| Δb* | −1.57 | 0.065 | 1.05 | 0.091 | |
| ∆E*ab | 2.54 | 0.088 | 1.34 | 0.090 |
| Ink | Color Change | BTA vs. BTB | p | AC vs. BC | p |
|---|---|---|---|---|---|
| Green | ΔL* | 25.30 | 0.037 | −1.40 | 0.038 |
| Δa* | 7.80 | 0.048 | 0.28 | 0.042 | |
| Δb* | 4.90 | 0.038 | 0.65 | 0.049 | |
| ∆E*ab | 29.20 | 0.026 | 1.33 | 0.023 | |
| Carbon black | ΔL* | −0.40 | 0.088 | −0.65 | 0.068 |
| Δa* | −1.65 | 0.091 | −0.42 | 0.084 | |
| Δb* | −1.33 | 0.075 | 1.00 | 0.062 | |
| ∆E*ab | 1.90 | 0.082 | 1.18 | 0.080 |
| Codes | Treatments | Details |
|---|---|---|
| 0 | Control | No ink addition |
| S | Soil mix | Soil sample extract [73] |
| C | Compost mix | Commercial compost extract [73] |
| Ps | Bacterial strain | Pure culture P. stutzeri 5190 strain DSMZ [58] |
| Ai | Fungal strain | Pure culture A. infectoria NIS4 strain, Dpt. Science, Unimol, Italy [60] |
Disclaimer/Publisher’s Note: The statements, opinions and data contained in all publications are solely those of the individual author(s) and contributor(s) and not of MDPI and/or the editor(s). MDPI and/or the editor(s) disclaim responsibility for any injury to people or property resulting from any ideas, methods, instructions or products referred to in the content. |
© 2024 by the authors. Licensee MDPI, Basel, Switzerland. This article is an open access article distributed under the terms and conditions of the Creative Commons Attribution (CC BY) license (https://creativecommons.org/licenses/by/4.0/).
Share and Cite
Ranalli, G.; Andreotti, A.; Colombini, M.P.; Corti, C.; Paris, D.; Rampazzi, L.; Saviano, G.; Vecchio, R.; Caprari, C. Investigation on Tattoo Ink (Hexadecachlorinate Copper Phthalocyanine) Removal: Novel Chemical and Biological Approach. Molecules 2024, 29, 5543. https://doi.org/10.3390/molecules29235543
Ranalli G, Andreotti A, Colombini MP, Corti C, Paris D, Rampazzi L, Saviano G, Vecchio R, Caprari C. Investigation on Tattoo Ink (Hexadecachlorinate Copper Phthalocyanine) Removal: Novel Chemical and Biological Approach. Molecules. 2024; 29(23):5543. https://doi.org/10.3390/molecules29235543
Chicago/Turabian StyleRanalli, Giancarlo, Alessia Andreotti, Maria Perla Colombini, Cristina Corti, Debora Paris, Laura Rampazzi, Gabriella Saviano, Ramona Vecchio, and Claudio Caprari. 2024. "Investigation on Tattoo Ink (Hexadecachlorinate Copper Phthalocyanine) Removal: Novel Chemical and Biological Approach" Molecules 29, no. 23: 5543. https://doi.org/10.3390/molecules29235543
APA StyleRanalli, G., Andreotti, A., Colombini, M. P., Corti, C., Paris, D., Rampazzi, L., Saviano, G., Vecchio, R., & Caprari, C. (2024). Investigation on Tattoo Ink (Hexadecachlorinate Copper Phthalocyanine) Removal: Novel Chemical and Biological Approach. Molecules, 29(23), 5543. https://doi.org/10.3390/molecules29235543

